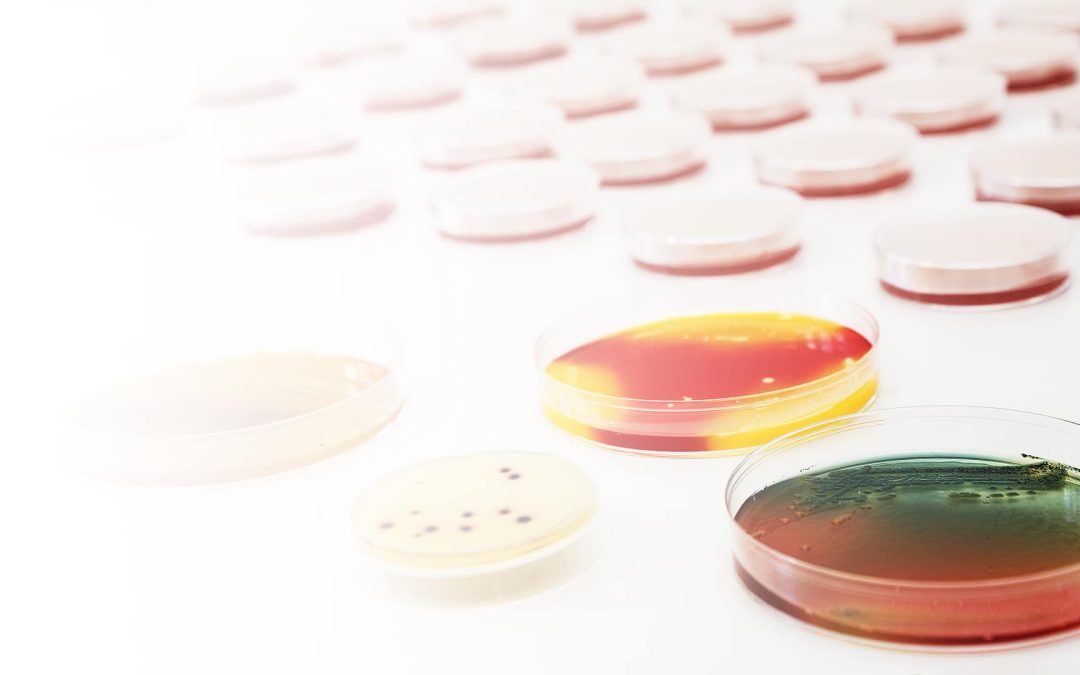
Prevenzione Legionella nelle strutture turistico ricettive

da admin | Set 21, 2022 | Novità
Con una comunicazione del 27 luglio l’INAIL ha introdotto una importante novità in materia di censimento delle strutture e dei manufatti contenenti amianto. Con l’entrata in vigore in data 14 luglio 2022 della norma UNI 11870:2022 è stato introdotto un nuovo iter...

da admin | Set 6, 2022 | Novità
La scheda informativa Inail “Campionamenti di polveri inalabili e respirabili”, pubblicata a luglio 2022, analizza i criteri di campionamento delle frazioni inalabile e respirabile delle polveri. L’apparato respiratorio è il sistema maggiormente esposto alle polveri;...

da admin | Mag 24, 2022 | Novità
Per Centri sportivi, Piscine, Centri Termali, Palestre e Strutture Ricettive Pageambiente offre un servizio di analisi acqua piscine, docce e impianti, con relativa redazione del Piano di Autocontrollo. Il servizio nasce per garantire, secondo quanto stabilito dalla...

da admin | Mag 22, 2022 | Novità
Cos’è la Legionella? Legionella è uno tra i patogeni più importanti trasmessi attraverso l’acqua, responsabile di una grave polmonite interstiziale denominata “malattia dei legionari”, generalmente nota come “legionellosi” e di una sindrome lieve simil-influenzale...

da admin | Dic 16, 2021 | Novità
Il sistema HACCP (Hazard Analisys e Critical Control Point) costituisce l’insieme delle normative comunitarie che regolamentano il settore alimentare e definisce gli obiettivi che le aziende devono perseguire in materia di sicurezza alimentare al fine di: prevenire la...